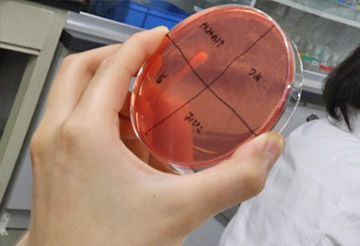
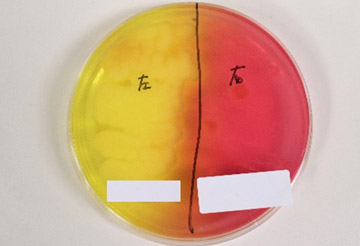
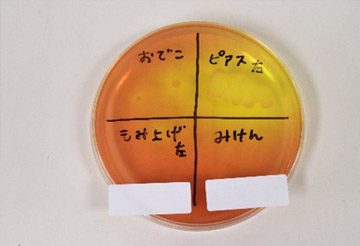

~ 食中毒注意報! ~
本格的な夏を目の前にジメジメした日が多くなってきていますが、体調はいかがでしょうか。「暑い・ジメジメした」と言えば、私達栄養士が気になるのは、『食中毒』です。
食中毒の原因は、細菌・ウイルス・寄生虫など様々ですが、その中でも最も多い原因は『細菌』によるもので、今の時期に多く発生しています(厚生労働省HPより)。武蔵野栄養専門学校では様々な授業で食中毒に関する項目を学びます。今回はその中から「食品衛生学実験」という授業で行っている『黄色ブドウ球菌の検査』についてご紹介していきたいと思います。
黄色ブドウ球菌の検査
-
1
-
- 食品衛生学実験は食品の安全性に影響を及ぼす微生物や化学物質の特性を理解し、実際の調理現場での衛生管理について指導・提案ができるよう実験を通して学ぶ科目で、本校では2年生の前期に行われています。今回の授業では、黄色ブドウ球菌がよく存在するといわれる鼻腔をはじめ、手指や腕、顔や耳のピアスの穴など、学生の調べてみたい部位の検査(湿らした綿棒で検査箇所をふき取り培地に塗抹し、その後48時間培養)し、観察をしていきます。
-
2
-
【黄色ブドウ球菌って何?】
- 『黄色ブドウ球菌』は私達の身近なところに存在しており、健康な人の鼻腔や咽頭、皮膚など自然界に広く分布していて、特に傷口からの検出率は高いとされています。食品中で増える細菌で、この菌が増殖する時に産生する毒素『エンテロトキシン』により食中毒が引き起こされます。エンテロトキシンは100℃、30分の加熱をしても死滅せず、『加熱に強い』という特徴があります。
-
3
-
【実験結果はこちら】
- 結果は写真をご覧ください!黄色ブドウ球菌は名前の通り黄色いコロニー(細菌の塊)を形成し、培地の色も赤色から黄色に変化し、コロニー周辺には不透明な部分が出てくるのが特徴です。シャーレの中には黄色や白色のコロニーが確認でき、私達の身の回りには黄色ブドウ球菌が存在しているということがわかりました。なお、白いコロニーを形成する菌は『表皮ブドウ球菌』の一種と考えられ、同じブドウ球菌の仲間ですが毒素を産生しません。
-
4
-
【授業担当の池田先生から】
- 今回の実験で体の色々な部分から黄色ブドウ球菌が検出されましたが、これは採取時の体調にも影響を受ける為、『菌が検出された=自分は危ない』、『菌は検出されなかった=自分は安全』という訳ではありません。大切なのは、食中毒の原因となるような菌を常に持っている可能性があることを意識し、常日頃から衛生管理に注意を払っていくということです。
ご存じの方も多いと思いますが、厚生労働省では、『食中毒予防のための3原則』を提唱しています。
-
①『つけない』・・・洗う、分ける
食中毒の原因となる細菌やウイルスを食品につけないよう、手洗いをしっかりしましょう。包丁やまな板などの調理器具は使用するごとに洗剤でよく洗い、また、肉や魚のドリップ(汁)が他の食品に付着しないよう保存、調理時にも注意が必要です。 -
②『増やさない』・・・低温で保存する
一般的に細菌は、10℃以下で増えにくくなります。購入した生鮮食品は、速やかに冷蔵庫や冷凍庫に入れて保存をしてください。 -
③『やっつける』・・・加熱処理
多くの細菌やウイルスは加熱によって死滅するので、特に肉や魚は中心部までしっかりと加熱をしましょう。私達栄養士は、食品の中心部が75℃以上で1分以上、ノロウイルスの汚染の恐れがある場合は85℃以上で90秒以上加熱するようにしています。
アーカイブ
- No.32冬の食中毒に注意!
- No.311年の始まりは縁起よく!
- No.30クリスマスの給食室から
- No.29日々の勤労に感謝!
- No.28どんな芋でも甘くなる秘密!
- No.27「もしも」と「いつも」をつなぐ食の備え
- No.26猛暑を乗り切る夏バテ予防メニュー
- No.25夏本番!BBQでは食中毒対策を万全に!
- No.24おいしい たのしい 食育
- No.23私が考えた献立はこちら!
- No.22お魚卸しに挑戦!
- No.21お祝いにおすすめちらし寿司!
- No.20すごいぞ・大豆
- No.19新年のごあいさつ
- No.18Merry Christmas!
- No.17血圧と向き合う(準備体操必須)!
- No.16食べて、治療をサポート
- No.15どっちにしようかな?
- No.14夏バテ対策に、この一品!
- No.13食中毒注意報!
- No.12冷めにくい汁物の秘密
- No.11MUSASHINOを体験!
- No.10身体で覚える
- No.09栄養士の卵たち、巣立ちます
- No.08みんなでシェア!
- No.07MUSASHINO最大のイベント!
- No.06あの子のプリンと私のプリン
- No.05やっぱりコシが命
- No.04高齢者の“食べる”を支える
- No.03夏休みの使命!
- No.02給食づくり奮闘記
- No.01本格的な実習の始まり